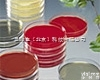
<em>培养基</em>E-MB61  <em>日本</em>荣研的<em>培养基</em>E-MB61

WAKO 培养基 日本和光纯药 现货列表货号 名称 规格
305-05901 HP-M199 (High Performance Medium 199) M199 GX培养基 5x100ml
308-14661 HP-M199 Hank?s (High Performance Medium 199 Hank?s) M199 HANK?S GX培养基 500ml
396-00871 LB Broth 50x100ml
393-00641 Gf 30ml
397-00281 Diluent With Lecthin & Polysorbate 80 5x30g
397-01521 Violet Red Bile Glucose Agar 300g
399-00861 Mycoplasma Broth Base 10x1L
397-01381 Nutrient Broth 300g
390-01371 Nutrient Agar 300g
WAKO 培养基 日本和光纯药 现货列表 子起生物 I368I6I966Z393-01643 Fluid Thioglycollate Medium 50x100ml
393-01621 Fluid Thioglycollate Medium 300g
397-01641 Fluid Thioglycollate Medium 10x100ml
392-01071 Selenite-Cystine Broth Base 300g
127-04421 Lymphocyte Sepration Medium (Mouse) 小鼠淋巴细胞分离培养基 5x30ml
305-14671 Cell Fusion Medium 2x100ml
632-03981 Fetal Bovine Serum, Gamma Irradiated 胎牛血清,γ照射 20x500ml
395-01061 Eosin-Methylene Blue Agar 300g
390-01131 Tsi Agar 300g
391-00441 Tsi Agar 100g
391-01041 Lactose Broth 300g
397-00301 Daigo Lactose Broth 300g
126-04871 Lymphocyte Separation Medium 1077 (For Human) 人淋巴细胞分离培养基6x100ml
018-15811 Agar Powder 100g
016-11875 Agar Powder 500g
012-11872 Agar Powder 25g
018-08721 Agar Powder 100g
016-08722 Agar Powder 25g
WAKO 培养基 日本和光纯药 现货列表 子起生物 I368I6I966Z398-00875 LB Broth 500g
393-00881 LB Agar 50x100ml
395-00885 LB Agar 500g
080-08565 Ham?s F-12K with L-Glutamine, Phenol Red and Sodium Pyruvate HAM?S F12 培养基,含L-谷氨酰胺和酚红和丙酮酸钠 500ml
087-08335 F-12 with L-Glutamine and Phenol Red HAM?S F12 培养基,含L-谷氨酰胺和酚红 500ml
397-00703 Ham?s F12 Medium (Powder) 10x1L
391-00701 Ham?s F12 Medium 10L
051-07615 E-MEM with L-Glutamine and Phenol Red E-MEM,含L-谷氨酰胺和酚红500ml
392-00351 EMB Agar,Levine 300g
392-00471 E C Medium 300g
393-00663 Eagle?s MEM (Powder) 10x1L
WAKO 培养基 日本和光纯药 现货列表 子起生物 I368I6I966Z397-00661 Eagle?s MEM 10L
308-05251 Embryo Culture Medium (Non-Coculture) 胚胎培养基(non-coculture) 5x10ml
307-05221 Bovine Embryo Freezing Medium 100ml
390-01295 Actino Medium No. 3 (Oatmeal Agar Medium) 麦片琼脂 500g
300-05211 Oocyte Collection Medium 5x100ml
301-05241 Oocyte Maturation And Embryo Culture Medium(Coculture) 卵母细胞成熟和胚胎培养基 5x25ml
399-00143 T.G.C. [Thioglycolate Culture Medium I ] 硫代乙醇酸盐培养基 I 450g
390-00293 Thioglycolate Culture Medium Ii 硫代乙醇酸盐培养基 II for10x1L
394-00291 Thioglycolate Culture Medium Ii 硫代乙醇酸盐培养基 II 300g
398-00451 Brilliant Green-Lactose-Bile Broth 亮绿乳糖胆汁肉汤 300g
394-00431 Brilliant Green Agar 300g
390-00411 Hajna Tetrathionate Broth 300g
399-01081 Tetrathionate Broth 300g
398-00831 Grace?s Insect Cell Culture Medium 昆虫细胞培养基 300g
395-00841 M.M Insect Cell Culture Medium 300g
392-00797 Dried Yeast Extract-S 10kg
WAKO 培养基 日本和光纯药 现货列表 子起生物 I368I6I966Z394-00671 Eagle?s MEM 10x500ml
397-00683 Dulbecco?s Modified Eagle Medium (Powder) DULBECCO?S 改良EAGLE培养基10x1L
391-00681 Dulbecco?s Modified Eagle Medium DULBECCO?S 改良EAGLE培养基 10L
045-30285 D-MED (High Glucose) with Phenol Red D-MEM(高糖),含酚红 500ml
044-29765 D-MEM (High Glucose) with L-Glutamine and Phenol Red D-MEM(高糖),含L-谷氨酰胺和酚红 500ml
304-05231 Fertilization Medium 5x30ml
304-05971 Basal Medium Embryo Culture 5x100ml
390-01631 Alternative Thioglycollate Medium 300g
390-00771 Gf 21 500ml
396-00773 Gf 21 10x500ml
010-08725 Agar Powder 500g
010-15815 Agar Powder 500g
390-00151 Polypepton 50g
394-00115 Polypepton 500g
398-00118 Polypepton 4x10kg
WAKO 培养基 日本和光纯药 现货列表 子起生物 I368I6I966Z390-00117 Polypepton 10kg
048-30275 D-MED (High Glucose) with L-Glutamine, Phenol Red and HEPES D-MEM(高糖),含L-谷氨酰胺,酚红,HEPES 500ml
043-30085 D-MEM (High Glucose) with L-Glutamine, Phenol Red and Sodium Pyruvate D-MEM(高糖),含L-谷氨酰胺,酚红和丙酮酸钠 500ml
041-29775 D-MEM (Low Glucose) with L-Glutamine and Phenol Red D-MEM(低糖),含L-谷氨酰胺和酚红 500ml
635-07295 D-MEM (with L-Glutamine & HEPES, Without Phenol Red) D-MEM,含L-谷氨酰胺和HEPES,不含酚红 500ml
390-00531 Extract Yeast, Dry D-3 (Dried Extract Of Yeast D-3) 酵母粉 D-3 250g
398-00537 Extract Yeast, Dry D-3 (Dried Extract Of Yeast D-3) 酵母粉 D-3 10kg
374-00571 Pseudomonas Broth 50x2ml
012-00941 Adonitol 1g
010-00942 Adonitol 25g
018-00943 Adonitol 5g
392-00851 Schneider?S Drosophila Medium 300g
319-01343 Hi-Competence Broth 20x1ml
637-07135 High Density Incubation Medium Kbm300, For Hybridoma 高密度孵育培养基KBM300,杂交瘤细胞用 500ml
635-07131 High Density Incubation Medium Kbm300, For Hybridoma 高密度孵育培养基KBM300,杂交瘤细胞用 1000ml
399-01265 Medium No. 5 (Glycerol-Asparagine Agar Medium) 甘油-天冬酰胺琼脂培养基 500g
399-00361 Mannitol Salt Agar 300g
391-00125 Polypepton S 500g
WAKO 培养基 日本和光纯药 现货列表 子起生物 I368I6I966Z397-00127 Polypepton S 10kg
395-00601 Polypepton P1 450g
183-02165 RPMI-1640 with Phenol Red 500ml
189-02025 RPMI-1640 with L-Glutamine and Phenol Red 1640培养基,含L-谷氨酰胺和酚红 500ml
186-02155 RPMI-1640 with L-Glutamine 500ml
391-00723 RPMI 1640 Medium (Powder) 10x1L
040-30095 D-MEM without L-Glutamine and Phenol Red D-MEM,不含L-谷氨酰胺和酚红500ml
048-29785 D-MEM / Ham?s F-12 with L-Glutamine and Phenol Red D-MEM / HAM?S F-12,含L-谷氨酰胺和酚红 500ml
395-01343 Medium for Marine Microalgae 10x1L
392-01331 IMK Medium for Marine Microalgae IMK 培养基(海藻类培养) 1000L
398-01333 IMK Medium for Marine Microalgae IMK 培养基(海藻类培养) 10x100L
394-00311 Cetrimide agar 300g
396-00371 Baird Parker Agar Base 100g
016-15812 Agar Powder 25g
016-15817 Agar Powder 10kg
WAKO 培养基 日本和光纯药 现货列表 子起生物 I368I6I966Z300-51621 Minimum Glucose Agar Broth 100sheet
391-00245 Daigo Glucose Peptone Broth With Lecithin & Polysorbate 80 葡萄糖蛋白胨肉汤,含卵磷脂和聚山梨醇酯 500g
397-00225 Daigo Glucose Peptone Broth 500g
394-00235 Daigo Glucose Peptone Agar With Lecithin & Polysorbate 80. 葡萄糖蛋白胨琼脂,含卵磷脂和聚山梨醇酯 500g
394-01031 Glucose Peptone Aga 300g
307-05961 Embryo Culture, Basal Medium 5x100ml
393-00521 Yeast Extract Powder 250g
391-00527 Yeast Extract Powder 10kg
395-00721 RPMI 1640 Medium 10L
393-01305 Actino Medium No. 6 (Peptone-Yeast Extract-Iron Agar Medium) 蛋白胨酵母粉-铁琼脂培养基 500g
398-01235 Actino Medium No. 1 (Peptone-Yeast Medium ) 蛋白胨酵母粉培养基 500g
392-00817 Soybean-Casein Digest Paste 12.5kg
390-01653 Soybean-Casein-Digest Broth 50x100ml
394-01651 Soybean-Casein-Digest Broth 10x100ml
396-00991 Soybean-Casein-Digest Broth 300g
395-01321 Soybean-Casein-Digest Broth 600g
393-00185 Daigo Soybean Casein Digest Broth大豆酪蛋白消化肉汤 500g
398-00255 Daigo Soybean Casein Digest Agar With Lecithin & Polysorbate 大豆酪蛋白消化琼脂,含卵磷脂和聚山梨醇酯 500g
WAKO 培养基 日本和光纯药 现货列表 子起生物 I368I6I966Z396-00175 Soybean-Casein Digest Agar 500g
399-00981 Soybean-Casein Digest Agar 300g
390-01511 Enterobacteria Enrichment Broth-Mossel肠道菌增菌肉汤培养基 300g
391-00321 Vogel-Johnson Agar 300g
395-00743 T Medium 2(Powder) 10x1L
399-00741 T Medium 2 10L
395-00581 T Medium 10x1L
391-00583 T Medium 10L
391-01541 SE-MET Core Medium 1L
399-01547 SE-MET Core Medium 10L
396-01091 Rappaprot Broth 300g
395-01681 R2A Broth 300g
396-01611 R2A Agar 300g
135-15175 MEMαwith L-Glutamine and Phenol Red MEMα,含L-谷氨酰胺和酚红 500ml
WAKO 培养基 日本和光纯药 现货列表 子起生物 I368I6I966Z
温馨提示:不可用于临床ZL。